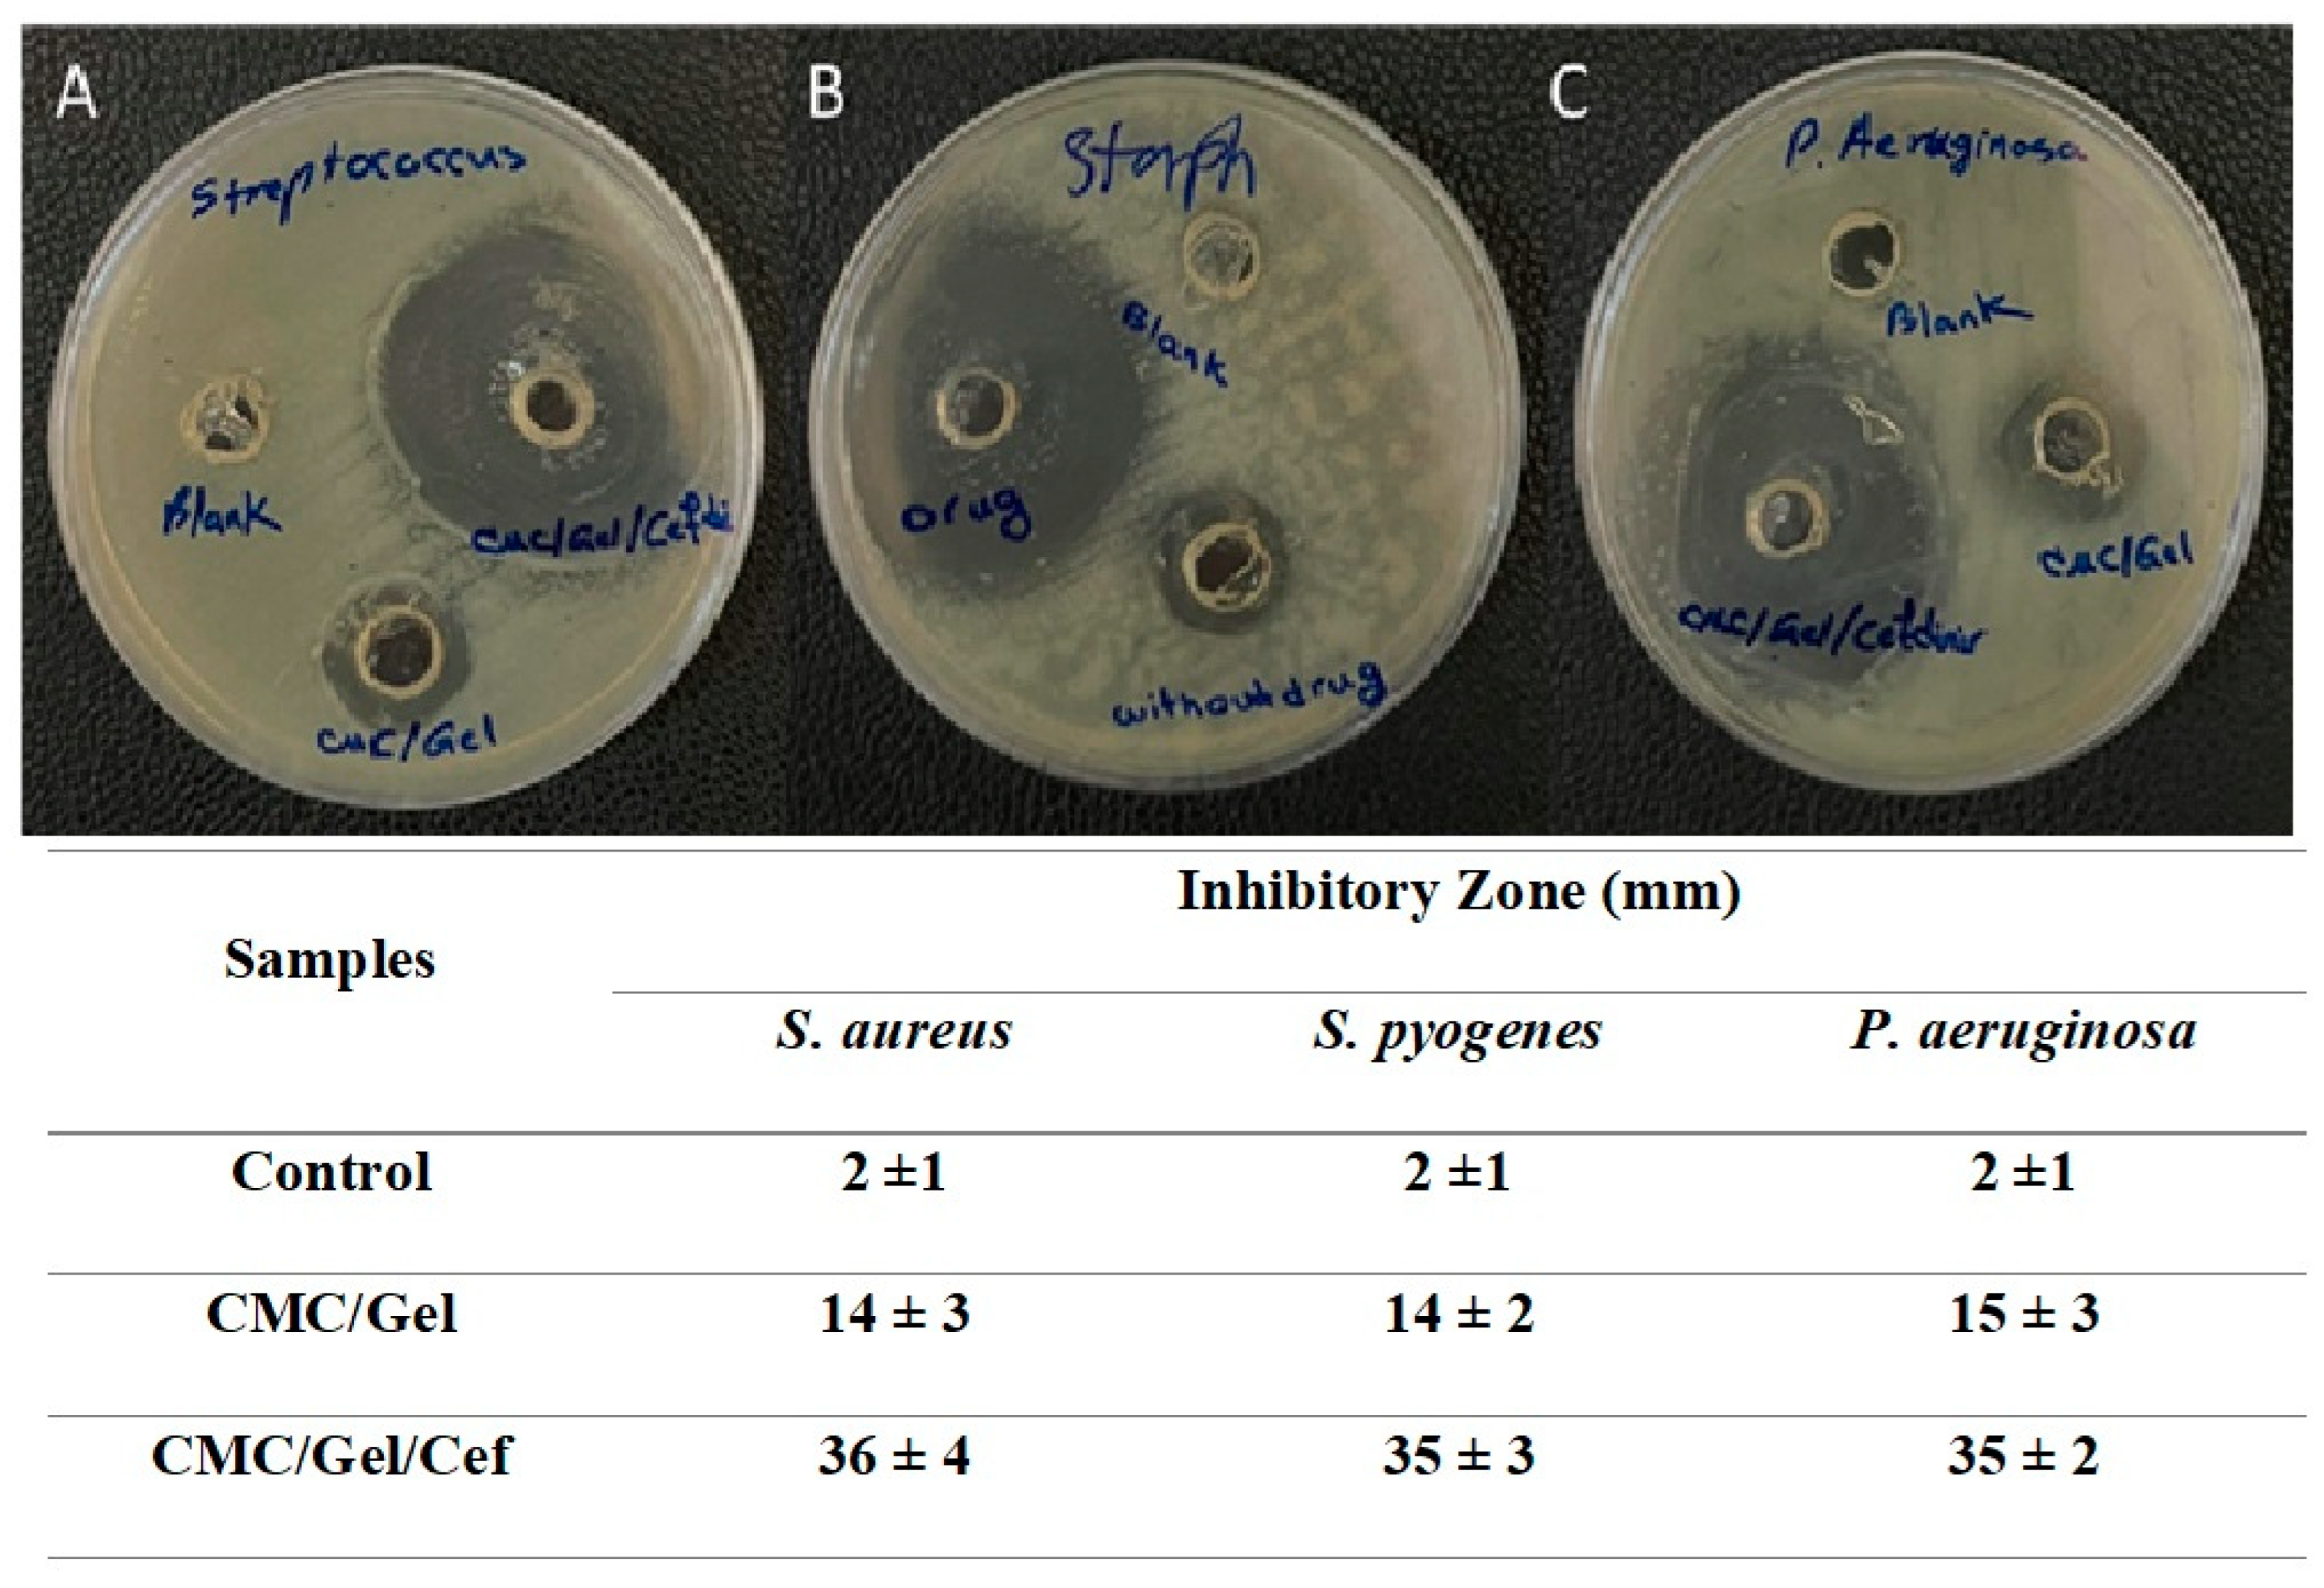
Preprints 141836 g006

Submitted:
04 December 2024
Posted:
06 December 2024
You are already at the latest version
Abstract

Keywords:
1. Introduction
2. Materials and Methods
2.1. Materials
2.2. Synthesis of CMC/Gel and CMC/Gel/Cef Hydrogels
2.3. Characterization of Hydrogels
2.3.1. Morphology Observation
2.3.2. Fourier Transform Infrared Spectroscopy (FTIR)
2.3.3. Tensile Testing
2.3.4. Swelling Test
2.3.5. Degradation Assessment
2.3.6. Antibacterial Activity
2.3.7. Cytotoxicity Test
2.3.8. In Vivo Investigation
2.4. Statistical Analysis
3. Results and Discussion
3.1. Characterization of Hydrogels
3.2. Fourier Transform Infrared Analysis
3.3. Mechanical Measurement
3.4. Swelling Behavior
3.5. Degradation Behavior
3.6. Antibacterial Activity
3.7. MTT Assay Results
3.8. Animal Study
4. Conclusion
Funding
Institutional Review Board Statement
Informed Consent Statement
Data Availability Statement
Conflicts of Interest
References
- Sheokand, B.; Vats, M.; Kumar, A.; Srivastava, C.M.; Bahadur, I.; Pathak, S.R. Natural Polymers Used in the Dressing Materials for Wound Healing: Past, Present and Future. J. Polym. Sci. 2023, 61, 1389–1414. [Google Scholar] [CrossRef]
- Liang, Y.; He, J.; Guo, B. Functional Hydrogels as Wound Dressing to Enhance Wound Healing. ACS Nano 2021, 15, 12687–12722. [Google Scholar] [CrossRef] [PubMed]
- Ndlovu, S.P.; Ngece, K.; Alven, S.; Aderibigbe, B.A. Gelatin-Based Hybrid Scaffolds: Promising Wound Dressings. Polymers (Basel). 2021, 13, 2959. [Google Scholar] [CrossRef] [PubMed]
- Kaya, S.; Ankara, S.D.-J. of F. of P. of; 2023, undefined Properties of Ideal Wound Dressing. dergipark.org.trS Kaya, S DermanJournal Fac. Pharm. Ankara Univ. 2023•dergipark.org.tr.
- Basu, P.; Narendrakumar, U.; Arunachalam, R.; Devi, S.; Manjubala, I. Characterization and Evaluation of Carboxymethyl Cellulose-Based Films for Healing of Full-Thickness Wounds in Normal and Diabetic Rats. ACS omega 2018, 3, 12622–12632. [Google Scholar] [CrossRef] [PubMed]
- Su, J.; Li, J.; Liang, J.; Zhang, K.; Li, J. Hydrogel Preparation Methods and Biomaterials for Wound Dressing. Life 2021, 11, 1016. [Google Scholar] [CrossRef]
- Kus, K.J.B.; Ruiz, E.S. Wound Dressings – A Practical Review. Curr. Dermatol. Rep. 2020, 9, 298–308. [Google Scholar] [CrossRef]
- Pan, Z.; Ye, H.; Wu, D. Recent Advances on Polymeric Hydrogels as Wound Dressings. APL Bioeng. 2021, 5, 11504. [Google Scholar] [CrossRef]
- Shen, Z.; Zhang, C.; Wang, T.; Xu, J. Advances in Functional Hydrogel Wound Dressings: A Review. Polymers (Basel). 2023, 15. [Google Scholar] [CrossRef] [PubMed]
- Alven, S.; Aderibigbe, B.A. Chitosan and Cellulose-Based Hydrogels for Wound Management. Int. J. Mol. Sci. 2020, 21, 9656. [Google Scholar] [CrossRef] [PubMed]
- Jia, B.; Li, G.; Cao, E.; Luo, J.; Zhao, X.; Huang, H. Recent Progress of Antibacterial Hydrogels in Wound Dressings. Mater. Today Bio 2023, 19, 100582. [Google Scholar] [CrossRef]
- Opt Veld, R.C.; Walboomers, X.F.; Jansen, J.A.; Wagener, F.A.D.T.G. Design Considerations for Hydrogel Wound Dressings: Strategic and Molecular Advances. Tissue Eng. Part B. Rev. 2020, 26, 230–248. [Google Scholar] [CrossRef] [PubMed]
- Song, P.; Wang, H. High-Performance Polymeric Materials through Hydrogen-Bond Cross-Linking. Adv. Mater. 2020, 32, 1901244. [Google Scholar] [CrossRef]
- Maitra, J.; Shukla, V.K. Cross-Linking in Hydrogels - A Review. Am. J. Polym. Sci. 2014, 4, 25–31. [Google Scholar] [CrossRef]
- Kanikireddy, V.; Varaprasad, K.; Jayaramudu, T.; Karthikeyan, C.; Sadiku, R. Carboxymethyl Cellulose-Based Materials for Infection Control and Wound Healing: A Review. Int. J. Biol. Macromol. 2020, 164, 963–975. [Google Scholar] [CrossRef] [PubMed]
- Rahman, M.S.; Hasan, M.S.; Nitai, A.S.; Nam, S.; Karmakar, A.K.; Ahsan, M.S.; Shiddiky, M.J.A.; Ahmed, M.B. Recent Developments of Carboxymethyl Cellulose. Polymers (Basel). 2021, 13, 1345. [Google Scholar] [CrossRef] [PubMed]
- Savencu, I.; Iurian, S.; Porfire, A.; Bogdan, C.; Tomuță, I. Review of Advances in Polymeric Wound Dressing Films. React. Funct. Polym. 2021, 168, 105059. [Google Scholar] [CrossRef]
- Burloiu, A.M.; Ozon, E.A.; Musuc, A.M.; Anastasescu, M.; Socoteanu, R.P.; Atkinson, I.; Culita, D.C.; Anuta, V.; Popescu, I.A.; Lupuliasa, D.; et al. Porphyrin Photosensitizers into Polysaccharide-Based Biopolymer Hydrogels for Topical Photodynamic Therapy: Physicochemical and Pharmacotechnical Assessments. Gels 2024, 10, 499. [Google Scholar] [CrossRef] [PubMed]
- Kang, J. Il; Park, K.M. Advances in Gelatin-Based Hydrogels for Wound Management. J. Mater. Chem. B 2021, 9, 1503–1520. [Google Scholar] [CrossRef] [PubMed]
- Ali, N.H.; Amin, M.C.I.M.; Ng, S.F. Sodium Carboxymethyl Cellulose Hydrogels Containing Reduced Graphene Oxide (RGO) as a Functional Antibiofilm Wound Dressing. J. Biomater. Sci. Polym. Ed. 2019, 30, 629–645. [Google Scholar] [CrossRef] [PubMed]
- Tottoli, E.M.; Dorati, R.; Genta, I.; Chiesa, E.; Pisani, S.; Conti, B. Skin Wound Healing Process and New Emerging Technologies for Skin Wound Care and Regeneration. Pharmaceutics 2020, 12. [Google Scholar] [CrossRef] [PubMed]
- Saghafi, Y.; Baharifar, H.; Najmoddin, N.; Asefnejad, A.; Maleki, H.; Sajjadi-Jazi, S.M.; Bonkdar, A.; Shams, F.; Khoshnevisan, K. Bromelain- and Silver Nanoparticle-Loaded Polycaprolactone/Chitosan Nanofibrous Dressings for Skin Wound Healing. Gels 2023, 9. [Google Scholar] [CrossRef]
- Perry, C.M.; Scott, L.J. Cefdinir: A Review of Its Use in the Management of Mild-to-Moderate Bacterial Infections. Drugs 2004, 64, 1433–1464. [Google Scholar] [CrossRef]
- Wang, H.; Liu, Y.; Cai, K.; Zhang, B.; Tang, S.; Zhang, W.; Liu, W. Antibacterial Polysaccharide-Based Hydrogel Dressing Containing Plant Essential Oil for Burn Wound Healing. Burn. trauma 2021, 9. [Google Scholar] [CrossRef] [PubMed]
- Montaser, A.S.; Jlassi, K.; Ramadan, M.A.; Selem, A.A.; Attia, M.F. Alginate, Gelatin, and Carboxymethyl Cellulose Coated Nonwoven Fabrics Containing Antimicrobial AgNPs for Skin Wound Healing in Rats. Int. J. Biol. Macromol. 2021, 173, 203–210. [Google Scholar] [CrossRef] [PubMed]
- Kilík, R.; Lakyová, L.; Sabo, J.; Kruzliak, P.; Lacjaková, K.; Vasilenko, T.; Vidová, M.; Longauer, F.; Radoňak, J. Effect of Equal Daily Doses Achieved by Different Power Densities of Low-Level Laser Therapy at 635 Nm on Open Skin Wound Healing in Normal and Diabetic Rats. Biomed Res. Int. 2014, 2014. [Google Scholar] [CrossRef] [PubMed]
- Yang, C.; Xu, L.; Zhou, Y.; Zhang, X.; Huang, X.; …, M.W.-C. ; 2010, undefined A Green Fabrication Approach of Gelatin/CM-Chitosan Hybrid Hydrogel for Wound Healing. ElsevierC Yang, L Xu, Y Zhou, X Zhang, X Huang, M Wang, Y Han, M Zhai, S Wei, J LiCarbohydrate Polym. 2010•Elsevier.
- Valadi, M.; Doostan, M.; Khoshnevisan, K.; Doostan, M.; Maleki, H. Enhanced Healing of Burn Wounds by Multifunctional Alginate-Chitosan Hydrogel Enclosing Silymarin and Zinc oxide nanoparticles. Burns 2024, 50. [Google Scholar] [CrossRef]
- Choi, D.J.; Park, S.J.; Gu, B.K.; Kim, Y.J.; Chung, S.; Kim, C.H. Effect of the Pore Size in a 3D Bioprinted Gelatin Scaffold on Fibroblast Proliferation. J. Ind. Eng. Chem. 2018, 67, 388–395. [Google Scholar] [CrossRef]
- Zafar, A.; Khosa, M.K.; Noor, A.; Qayyum, S.; Saif, M.J. Carboxymethyl Cellulose/Gelatin Hydrogel Films Loaded with Zinc Oxide Nanoparticles for Sustainable Food Packaging Applications. Polym. 2022, 14, 5201. [Google Scholar] [CrossRef] [PubMed]
- Cabri, W.; Ghetti, P.; Alpegiani, M.; Pozzi, G.; Justo-Erbez, A.; Pérez-Martínez, J.I.; Villalón-Rubio, R.; Monedero-Perales, M.C.; Muñoz-Ruiz, A. Cefdinir: A Comparative Study of Anhydrous vs. Monohydrate Form: Microstructure and Tabletting Behaviour. Eur. J. Pharm. Biopharm. 2006, 64, 212–221. [Google Scholar] [CrossRef]
- Kong, D.; Zhang, Q.; You, J.; Cheng, Y. ; C.H.-C.; 2020, undefined Adhesion Loss Mechanism Based on Carboxymethyl Cellulose-Filled Hydrocolloid Dressings in Physiological Wounds Environment. ElsevierD Kong, Q Zhang, J You, Y Cheng, C Hong, Z Chen, T Jiang, T HaoCarbohydrate Polym. 2020•Elsevier.
- He, M.; Ou, F.; Wu, Y.; Sun, X.; Chen, X.; Li, H.; Sun, D.; Zhang, L. Smart Multi-Layer PVA Foam/ CMC Mesh Dressing with Integrated Multi-Functions for Wound Management and Infection Monitoring. Mater. Des. 2020, 194. [Google Scholar] [CrossRef]
- Neacsu, I.A.; Leau, S.A.; Marin, S.; Holban, A.M.; Materials, B.S.V.-. ; 2021, undefined Collagen-Carboxymethylcellulose Biocomposite Wound-Dressings with Antimicrobial Activity. mdpi.comIA Neacsu, SA Leau, S Mar. AM Holban, BS Vasile, AI Nicoara, VL Ene, C BleotuMaterials, 2021•mdpi.com.
- Capanema, N.S. V; Mansur, A.A.P.; de Jesus, A.C.; Carvalho, S.M.; de Oliveira, L.C.; Mansur, H.S. Superabsorbent Crosslinked Carboxymethyl Cellulose-PEG Hydrogels for Potential Wound Dressing Applications. Int. J. Biol. Macromol. 2018, 106, 1218–1234. [Google Scholar] [CrossRef] [PubMed]
- Rottmar, M.; Richter, M.; Mder, X.; Grieder, K.; Nuss, K.; Karol, A.; Rechenberg, B. Von; Zimmermann, E.; Buser, S.; Dobmann, A.; et al. In Vitro Investigations of a Novel Wound Dressing Concept Based on Biodegradable Polyurethane. Sci. Technol. Adv. Mater. 2015, 16. [Google Scholar] [CrossRef] [PubMed]
- Sultan, T.; Baltch, A.L.; Smith, R.P.; Ritz, W. In Vitro Activity of Cefdinir (FK482) and Ten Other Antibiotics against Gram-Positive and Gram-Negative Bacteria Isolated from Adult and Pediatric Patients. Chemotherapy 1994, 40, 80–91. [Google Scholar] [CrossRef] [PubMed]
- Tu, Z.; Zhong, Y.; Hu, H.; Shao, D.; Haag, R.; Schirner, M.; Lee, J.; Sullenger, B.; Leong, K.W. Design of Therapeutic Biomaterials to Control Inflammation. Nat. Rev. Mater. 2022, 7, 557–574. [Google Scholar] [CrossRef] [PubMed]
- Davenport Huyer, L.; Pascual-Gil, S.; Wang, Y.; Mandla, S.; Yee, B.; Radisic, M. Advanced Strategies for Modulation of the Material–Macrophage Interface. Adv. Funct. Mater. 2020, 30, 1909331. [Google Scholar] [CrossRef]

| Days and groups | ||||||||||
|---|---|---|---|---|---|---|---|---|---|---|
| 4th day | 9th day | 14th day | ||||||||
| c | a | b | c | a | b | c | a | b | ||
| Assayed factors | Epithelization | 0 | 0 | 0 | 1 | 2 | 2 | 3 | 3 | 4 |
| Inflammatory cells | 3 | 3 | 3 | 3 | 2 | 2 | 2 | 2 | 1 | |
| New Vessels | 3 | 3 | 3 | 3 | 2 | 2 | 2 | 2 | 2 | |
| Fibroblasts | 1 | 1 | 1 | 1 | 2 | 3 | 3 | 3 | 4 | |
| Collagen | 0 | 0 | 1 | 1 | 2 | 2 | 2 | 3 | 3 | |
Disclaimer/Publisher’s Note: The statements, opinions and data contained in all publications are solely those of the individual author(s) and contributor(s) and not of MDPI and/or the editor(s). MDPI and/or the editor(s) disclaim responsibility for any injury to people or property resulting from any ideas, methods, instructions or products referred to in the content. |
© 2024 by the authors. Licensee MDPI, Basel, Switzerland. This article is an open access article distributed under the terms and conditions of the Creative Commons Attribution (CC BY) license (http://creativecommons.org/licenses/by/4.0/).
